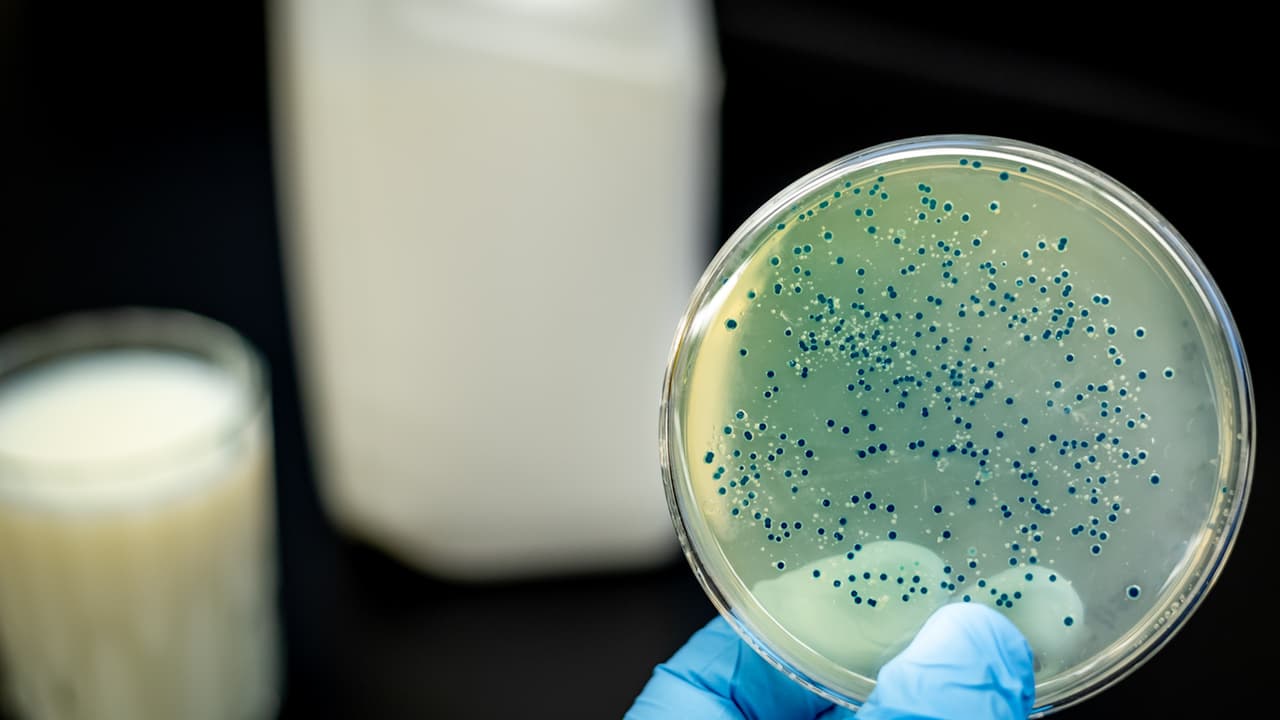
Lyons Magnus retira del mercado 53 productos por posible contaminación de Cronobacter

contaminación alimentaria
contaminación alimentaria: Últimas noticias, videos y fotos de contaminación alimentaria
¿Usas estas botellas para el agua? Estudio dice que tienen 40,000 veces más bacterias que los inodoros
¿Pensabas que cargar una botella reutilizable era más saludable que beber del grifo o de botellitas de plástico? Un estudio acaba de revelar que estas botellas tienen miles de bacterias y pueden probocar muchas enfermedades.
LO MÁS RECIENTE

Ese mensaje sobre arroz Dana "contaminado" de Pakistán es falso y reciclado
A través del chatbot de elDetector nos llegó una advertencia sobre un arroz importado de Pakistán, marca “Dana”, que supuestamente estaba “muy contaminado” y así se comercializa. Es una desinformación que circula al menos desde 2017. (Haz clic aquí para chatear con nosotros y enviarnos lo que quieras que verifiquemos).
Establecen nuevos estándares federales en el condado Wake para garantizar la seguridad alimentaria
Con el fin de evitar enfermedades infecciosas en restaurantes, el condado Wake anunció que en sus visitas sanitarias usará nuevos estándares federales. El dueño de un negocio en Raleigh opinó al respecto.

Más de 400 productos alimenticios son retirados del mercado debido a una posible contaminación con listeria
Según los Centros para el Control y la Prevención de Enfermedades cerca de 1,600 personas contraen listeriosis cada año y unas 260 de ellas mueren por la infección. Los productos contaminados fueron vendidos en Carolina del Norte, Carolina del Sur, Connecticut, Maryland, Massachusetts, Nueva Jersey, Nueva York, Pennsylvania, Virginia y el Distrito de Columbia.
SunSprout retira del mercado sus brotes de alfalfa por posible contaminación con salmonela
La compañía anunció el retiro voluntario de las bolsas de 4 onzas que fueron enviadas a tiendas de Nebraska, Kansas y Iowa. También aconsejaron a cualquier persona que tenga el producto que lo deseche de inmediato.
Puedes ver más noticias gratis
aquí.
Cuidado con el recalentado navideño porque podría ser peligroso
Durante la temporada festiva, muchos disfrutan del tradicional recalentado navideño; sin embargo, los CDC recuerdan que esto puede ser peligroso y causar intoxicación, por lo que emiten algunas recomendaciones para guardar adecuadamente la comida.
Consejos para guardar las sobras de la cena de Thanksgiving
Si ya disfrutaste del recalentado y aún sobran alimentos de la cena de Día de Acción de Gracias, te decimos cómo debes guardar la comida para disfrutarla por más días de forma segura, sin que te enfermes.